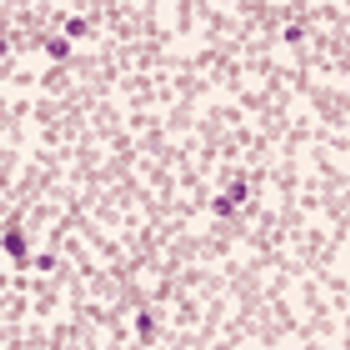
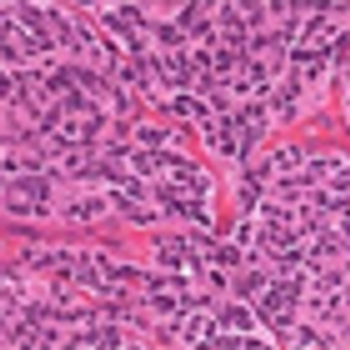
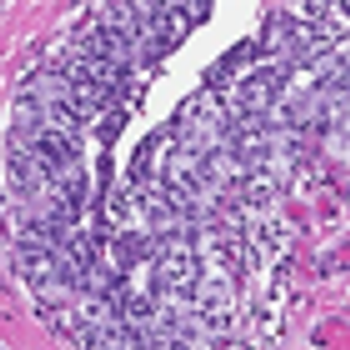
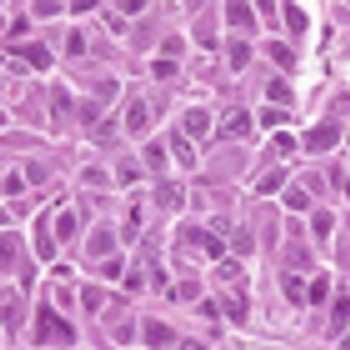
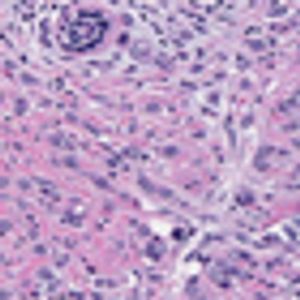
Human Lobular Breast Cancer

Robert D. Cardiff, MD, PhD
Advertisement
Articles by Robert D. Cardiff, MD, PhD
Advertisement
Latest Updated Articles
Neoplasm Lacking the Usual Genetic Markers Associated With Colorectal NeoplasmsPublished: April 7th 2011 | Updated:
Human Lobular Breast CancerPublished: March 25th 2011 | Updated:
Peripheral Blood Showing Markedly Increased WBCPublished: April 21st 2011 | Updated:
Mass Found in Left Kidney of Patient With von Hipple-Lindau SyndromePublished: May 5th 2011 | Updated:
Adenocarcinoma of the ProstatePublished: May 20th 2011 | Updated:
Core Biopsy of Prostate From an Elderly MalePublished: June 3rd 2011 | Updated:
Advertisement
Advertisement
Trending on CancerNetwork
1
Modifiable Risk Factors Suggest Potential for Improving Cancer Prevention
2
2026 Tandem Meetings: What’s the Latest Research in Multiple Myeloma?
3
Barriers to CAR T-Cell Referral and Center Access in Multiple Myeloma
4
Dato-DXd Receives Priority Review in Unresectable/Metastatic TNBC
5